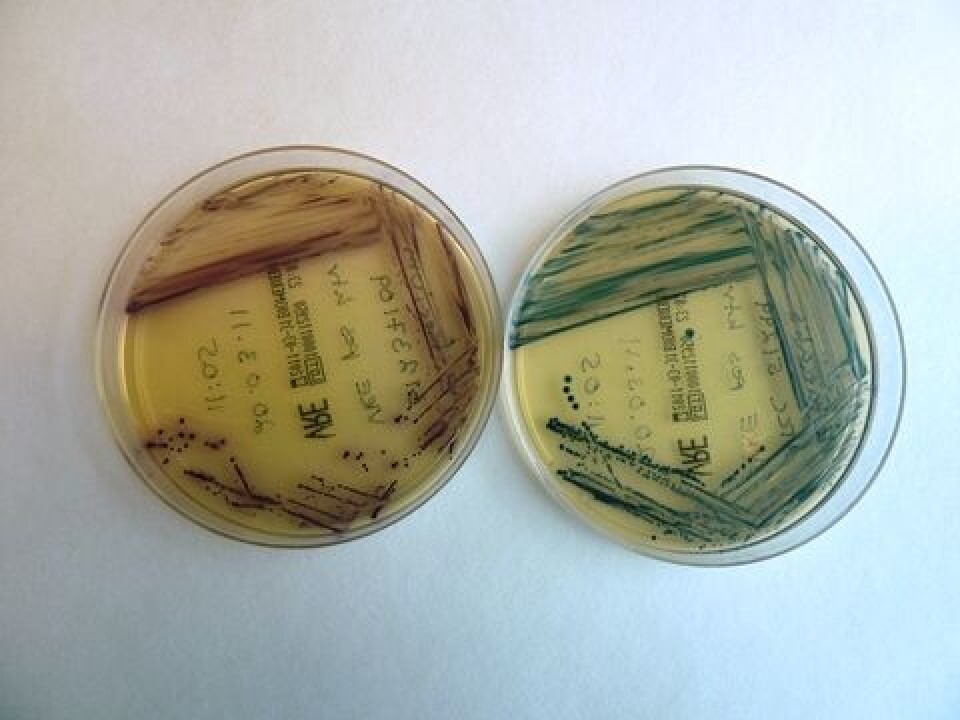

FAG i praksis

Utbrudd av vankomycinresistente enterokokker på Haukeland universitetssjukehus
Sommeren 2010 ble det påvist vankomycinresistente enterokokker i prøver fra to pasienter ved Haukeland universitetssjukehus. I september ble det påvist to tilfeller til, og man fikk mistanke om et utbrudd.
Resistente bakterier er et internasjonalt økende problem. Fremdeles er resistenssituasjonen i Norge gunstig sammenlignet med andre land, men den er stadig økende.
Ubruddet av vankomycinresistente enterokokker (VRE) på Haukeland universitetssjukehus (HUS) er Norges første VRE-utbrudd på sykehus. Det pågår fremdeles nå, i juni 2011.
Vankomycinresistente enterokokker
Enterokokker er bakterier som normalt finnes i tarmfloraen hos mennesker og dyr. De er robuste, og kan leve lenge i miljøet. Enterokokker er ikke høyvirulente bakterier, og som oftest gir bakterien asymptomatisk bærerskap i tarmen. Immunsvekkede pasienter er mer utsatt for sykdom, og bakterien kan være årsak til sykehusinfeksjoner som urinveisinfeksjoner, postoperative sårinfeksjoner og endokarditt. De klinisk viktigste enterokokkene er E. faecalis og E. faecium. De kan normalt behandles med antibiotika.
VRE regnes som en multiresistent mikrobe siden den er resistent for ulike antibiotikagrupper.
Bakterien har en ervervet glykopeptidresistens betinget av resistensgenene vanA og vanB.
VanA VRE er resistent mot både vankomycin og teikoplanin, mens vanB er resistent mot vankomycin og er teikoplanin sensitiv. Utbruddet på HUS er forårsaket av E. faecium med vanB resistens.
Tidligere er det bare påvist sporadiske tilfeller av VRE i Norge, mindre enn ti tilfeller hvert år, men VRE er ikke uvanlig i andre land. Sverige har hatt flere store sykehusutbrudd med VRE de siste årene.
Utbruddet ved HUS
Normalt påviser Mikrobiologisk avdeling ved HUS 0-2 tilfeller av VRE i året. Da det i løpet av fire måneder ble funnet fire tilfeller, og tre av dem kom fra samme sengepost, mistenkte man et utbrudd. Det ble straks satt i gang screening av den aktuelle sengeposten, og mistanken ble bekreftet. Pasientene som fikk påvist VRE ble isolert, og etter en stund ble det innført inntaksstopp på den aktuelle sengeposten. Lokalene ble vasket ned, og da utbruddet var under kontroll, ble andre nærliggende sengeposter og sengeposter med kliniske isolat, screenet.
Mikrobiologisk avdeling og Senter for smittevern ved HUS har i samarbeid skaffet oversikt over VRE-utbruddet, og i fellesskap planlegger vi hvilke sengeposter som skal screenes. Sengeposter med påvist nysmitte blir screenet én gang i uken. Sengeposter hvor det ikke er påvist nye VRE-tilfeller de siste ukene, screenes en gang per 14. dag. Mikrobiologisk avdeling mottar cirka 100 prøver per uke.

Valg av metode
I begynnelsen av utbruddet ble det nødvendig med rask tilgang på medier for påvisning av VRE. ChromIDTM VRE skål fra Biomerieux ble valgt. Siden VRE ikke er vanlig i Norge var det få skåler på lager, og lageret som fantes i Skandinavia ble fort brukt opp.
Siden det trengtes svært mange skåler for å screene sengepostene, testet vi ut egenproduserte skåler og buljong. For eksempel en VRE-anrikningsbuljong som blant annet inneholder Enterococcosel broth og 6 mg/l vankomycin. Den kunne leses av etter 24 timer, og positive prøver ble undersøkt på vanB resistensgen med PCR.
Å produsere egne skåler/anrikningsbuljong har mange fordeler. De er blant annet raskt tilgjengelig og kan lages etter behov. Men det krever mye ressurser å validere nye metoder. Under dette utbruddet ble prøvemengden for stor til å validere nye metoder samtidig.

Utsåing og påvisning
Penselprøve fra rektum blir sådd ut på en selektiv skål for VRE; ChromIDTM VRE. Den inneholder en blanding av antibiotika, blant annet 8 mg/l vankomycin. Skålen inneholder to kromogene substanser, som gir henholdsvis lilla kolonier (E. faecium) og grønne kolonier (E.faecalis). Skålene blir lest av etter 24 timer og etter 48 timer. Dersom det er vekst, leveres prøven videre til identifikasjon. Det blir da kjørt vanB PCR på kolonier fra ChromIDTM VRE-skålen. Dersom PCR er positiv, blir sengeposten varslet om mulig positiv VRE. Mikroben blir deretter isolert på blodskål, identifisert med Vitek-ID og resistensbestemt med E-test for vancomycin og teikoplanin. Positive VRE meldes til Senter for smittevern og MSIS. Det er planlagt å kjøre alle positive VRE på pulsfelt gelelektroforese (PFGE) for molekylær epidemiologisk karakterisering av utbruddet.
Hele sykehuset screenes
Fra sommeren 2010 til og med mai 2011 har Mikrobiologisk avdeling undersøkt cirka 2600 pasientprøver for VRE. Det er funnet 195 pasienter som er kolonisert med VRE. Det er påvist VRE-isolat fra blodkultur hos tre pasienter. Den ene pasienten døde, de to andre ble friske. Disse tre pasientene var alvorlig syke før de ble smittet av bakterien, og det er usikkert om bakterien er årsaken til dødsfallet.
Til nå er cirka en fjerdedel av de positive VRE-prøvene analysert med PFGE. Resultatene tyder på et klonalt utbrudd, det vil si at pasientene er smittet av den samme bakteriestammen. Foreløpig er en fjerdedel av avdelingene på HUS screenet, men det er planlagt å screene hele sykehuset for å få oversikt over forekomsten av VRE.

Tiltak
Tiltakene ved et utbrudd som det vi har ved HUS nå, må være hensiktsmessige i forhold til målene, de må være gjennomførbare og pasienter som er smittet av antibiotikaresistente bakterier må behandles spesielt for å unngå videre smitte.
Screening av pasienter på sengepostene er viktig for å få oversikt over hvem som er smittet, og smittede pasienter må isoleres fra dem som ikke er smittet. Det kan være både vanskelig og ressurskrevende å isolere og behandle pasientene.
Dersom vi ikke klarer å begrense VRE-infeksjonen, frykter vi at den smittsomme resistensen kan overføres til stafylokokker - i verste tilfelle til MRSA (Meticillinresistente Stafylococcus aureus).
Den vanligste smittemåten er kontaktsmitte via forurensede hender. Håndhygiene er derfor det viktigste enkelttiltaket for å hindre smitte og forebygge infeksjoner. Basale smittevernrutiner for alt helsepersonell må innskjerpes med pasientkontakt. Det er også nødvendig med innskjerping av håndhygienen for pasienter og besøkende. De kliniske avdelingene er anbefalt å redusere bruken av bredspektret antibiotika (for eksempel tredje generasjons cefalosporiner), siden bruken av dem bidrar til økt resistens. Bærere som ikke er syke skal ikke behandles med antibiotika. Ved HUS er det kun pasienter med infeksjon som blir behandlet med antibiotika. Sykehuspersonell, pårørende og andre utenfor sykehuset blir ikke testet.
Det er viktig at mikrobiologiske laboratorier har gode rutiner for påvisning av resistente mikrober, og at de kan gi hurtig svar til sengepostene for å iverksette eventuell isolering.